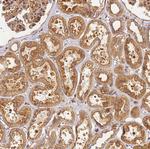
DYNC1I2 Antibody in Immunohistochemistry (Paraffin) (IHC (P))

Search
Invitrogen
DYNC1I2 Polyclonal Antibody
{{$productOrderCtrl.translations['antibody.pdp.commerceCard.promotion.promotions']}}
{{$productOrderCtrl.translations['antibody.pdp.commerceCard.promotion.viewpromo']}}
{{$productOrderCtrl.translations['antibody.pdp.commerceCard.promotion.promocode']}}: {{promo.promoCode}} {{promo.promoTitle}} {{promo.promoDescription}}. {{$productOrderCtrl.translations['antibody.pdp.commerceCard.promotion.learnmore']}}

Please note: We are reviewing Western blot images included in the antibody testing data in our catalog, including those provided by third parties. Unless expressly labeled or annotated as “raw-unedited”, Western blot images included in the antibody testing data in our catalog may have been edited, optimized or otherwise adjusted for presentation.
产品信息
PA5-59226
种属反应
宿主/亚型
分类
类型
抗原
偶联物
形式
浓度
规格
纯化类型
保存液
内含物
保存条件
运输条件
RRID
产品详细信息
Immunogen sequence: HSDSDLGRGP IKLGMAKITQ VDFPPREIVT YTKETQTPVM AQPKEDEEE
Highest antigen sequence identity to the following orthologs: Mouse - 98%, Rat - 98%.
靶标信息
Dyneins are multi-subunit, high molecular weight ATPases that interact with microtubules to generate force by converting the chemical energy of ATP into the mechanical energy of movement. Cytoplasmic or axonemal Dynein heavy, intermediate, light and light-intermediate chains are all components of minus end-directed motors; the complex that transports cellular cargos towards the central region of the cell. Axonemal Dynein motors contain one to three non-identical heavy chains and cause a sliding of microtubules in the axonemes of cilia and flagella in a mechanism necessary for cilia to beat and propel the cell. Cytoplasmic Dynein is an approximately 12 subunit complex of two heavy chains, two intermediate chains to anchor Dynein to its cargo, four smaller intermediate chains and several light chains. It performs functions necessary for cell survival such as organelle transport and centrosome assembly. The carboxy-terminus of Dynein is important for microtubule-dependent motility and is highly conserved, while the amino-terminal regions are more variable. Several proteins regulate Dynein activity, including Dynactin, LIS1 and nudel (nudE-like).
仅用于科研。不用于诊断过程。未经明确授权不得转售。
篇参考文献 (0)
生物信息学
蛋白别名: Cytoplasmic dynein 1 intermediate chain 2; Cytoplasmic dynein intermediate chain 2; DH IC-2; Dynein intermediate chain 2, cytosolic
基因别名: DNCI2; DNCIC2; DYNC1I2
Entrez Gene ID: (Human) 1781




